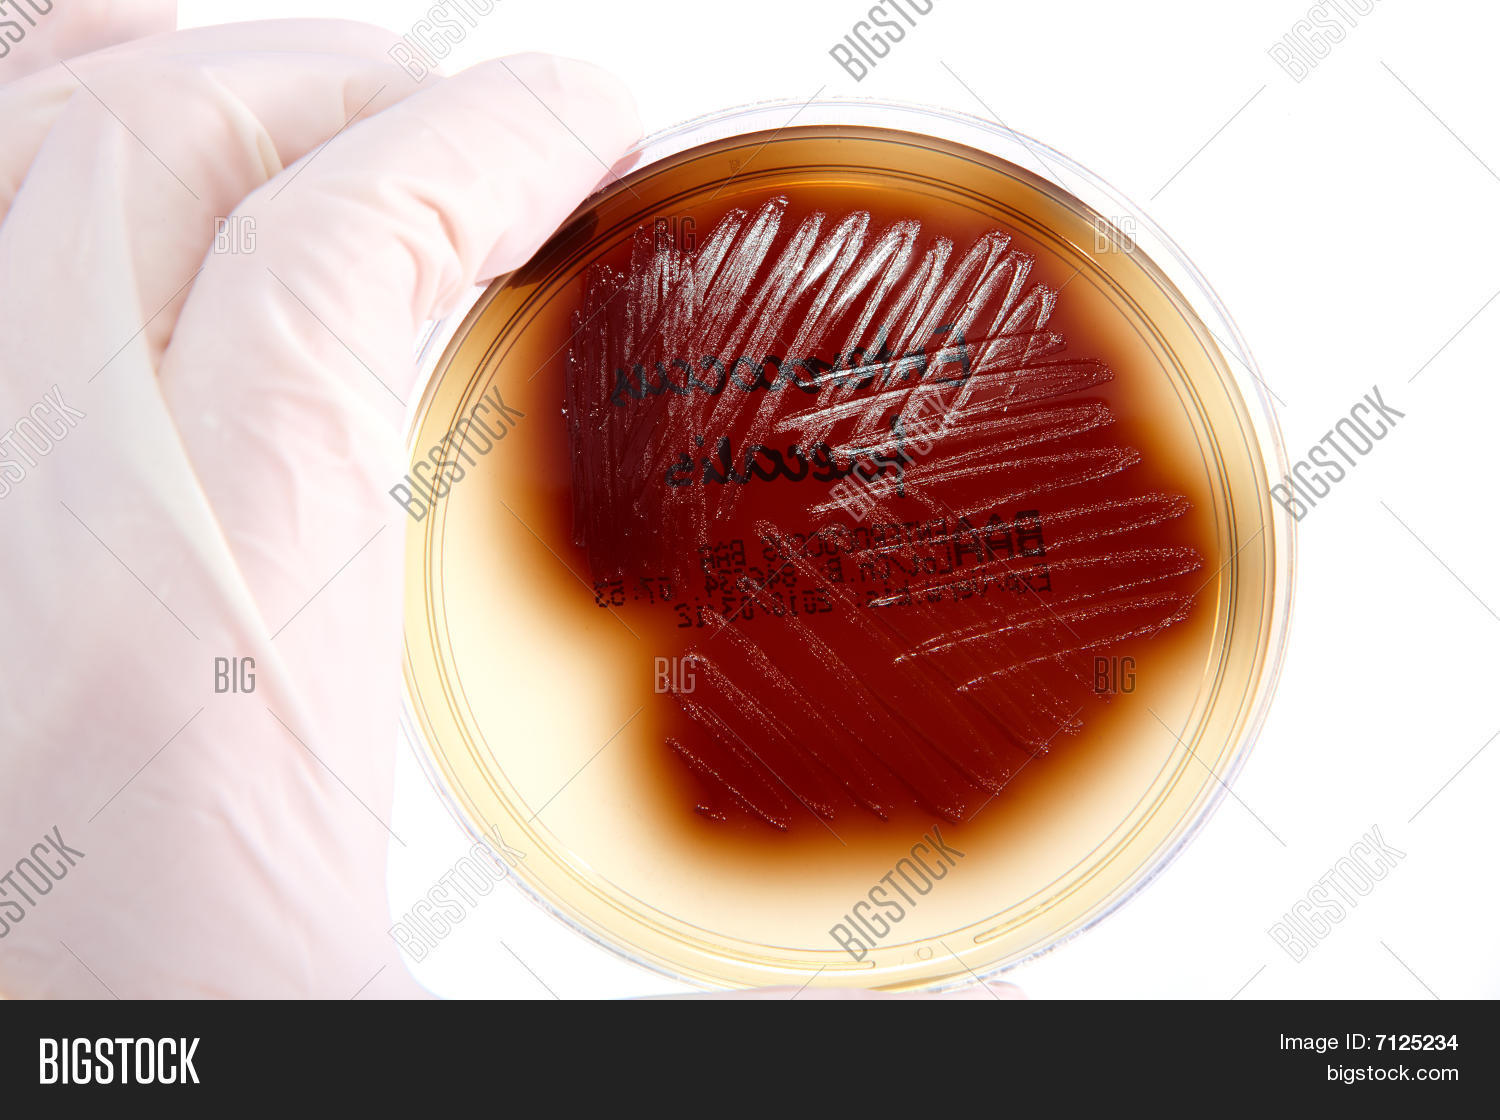

Понижен энтерококк
Подшипники кондиционера тигуан
Судебный пристав весны 9
Открытка здравствуй лето
Питомник сад пионов
Смесь co2 n2
Обновление teyes spro
Спа отеле аквамарин
Кто лучше йорк
Петли для входных
Jujutsu craft 1.20
Самые быстрые машины cyberpunk
Архипо осиповка снять жилье сентябрь 2025
Размер кольца в см 6
Понижен энтерококк 112 фотографий